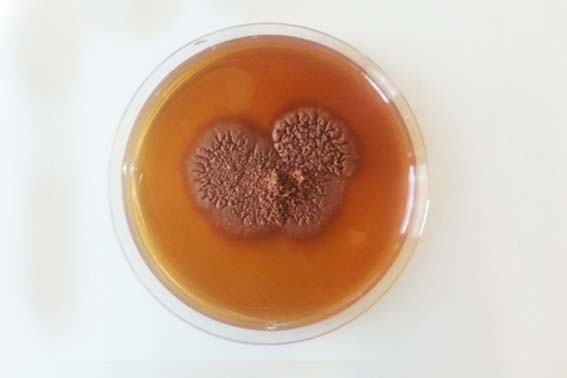

Mycetoma, chromoblastomycosis and other deep mycoses
Mycetoma is a chronic, progressively destructive morbid inflammatory disease usually of the foot but any part of the body can be affected. Infection is most probably acquired by traumatic inoculation of certain fungi or bacteria into the subcutaneous tissue. Mycetoma was described in the modern literature in 1694 but was first reported in the mid-19th century in the Indian town of Madura, and hence was initially called Madura foot.
Mycetoma commonly affects young adults, particularly males aged between 20 and 40 years, mostly in developing countries. People of low socioeconomic status and manual workers such as agriculturalists, labourers and herdsmen are the worst affected.
Mycetoma has numerous adverse medical, health and socioeconomic impacts on patients, communities and health authorities.
As mycetoma is a badly neglected disease, accurate data on its incidence and prevalence are not available.
Mycetoma is characterized by a triad of painless subcutaneous mass, multiple sinuses and discharge containing grains. It usually spreads to involve the skin, deep structures and bone resulting in destruction, deformity and loss of function, which may be fatal. Mycetoma commonly involves the extremities, back and gluteal region.
Given its slow progression, painless nature, massive lack of health education and scarcity of medical and health facilities in endemic areas, many patients present late with advanced infection where amputation may be the only available treatment. Secondary bacterial infection is common, and lesions may cause increased pain and disability and fatal septicaemia (severe infections involving the entire human system) if untreated. Infection is not transmitted from human to human.
The treatment depends on the causative organisms for the bacterial causes; it is a long term antibiotics combination whereas for the fungal type, treatment requires combined antifungals drugs and surgery. The treatment is unsatisfactory, has many side effects, is expensive and not available in most endemic areas.
Mycetoma is not a notifiable disease (a disease required by law to be reported) and no surveillance systems exist. There no preventable or control programmes for mycetoma yet. Preventing infection is difficult, but people living in or travelling to endemic areas should be advised not to walk barefooted.